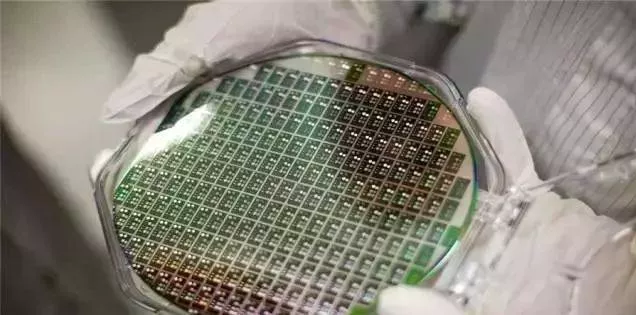

慣犯!為打壓中國射頻芯片發展,2015年美國誘捕中國科學家,並竊取專利_風聞
大眼联盟-2021-12-14 01:12
最近,遲到了3個月的華為P50系列終於發佈,儘管還有麒麟9000版本,但是卻不支持5G,之所以會這樣,是和美國對華為的地4輪制裁有關。
在第四輪制裁中,美國限制華為的器件供應商只要涉及美國技術的產品,就不允許供應給華為的5G設備。

射頻芯片是什麼
正因為如此,華為無法使用5G射頻芯片,來給手機提供5G信號的接收和發送。什麼是射頻芯片,射頻芯片就是負責將電磁波信號和數字信號直接的轉換,在手機終端中,最重要的核心就是射頻芯片和基帶芯片。射頻芯片負責射頻收發、頻率合成、功率放大;基帶芯片負責信號處理和協議處理。
具體而言,射頻芯片包括RF收發機、 功率放大器(PA) 、 低噪聲放大器(LNA) 、 濾波器、 射頻開關(Switch) 、 天線調諧開關(Tuner) 等。其中濾波器和功率放大器是射頻芯片的核心部件,什麼是濾波器,聲音要傳到千里之外,得先轉化成高頻的射電波。信息編碼成一秒鐘幾十億波峯的正弦電波,對方手機接收和還原,紋絲不亂,根據數據統計,濾波器佔據了射頻前端市場中的最大份額,,而PA佔約30%,至於射頻開關和LNA佔約10%,其他佔約10%。
而到了5G時代,對射頻芯片的需求更高,5G手機為例,單部手機的射頻用量達到25美元,相比4G近乎翻倍。其中濾波器從40個增加至70個,PA從4G的5-7顆到5G所需的16顆之多。同時,PA的單價也有顯著提高,從4G手機的3.25美元躍升至5G手機的7.5美元以上。

根據研究機構的數據顯示,現在全球93%的PA供應集中在 Skyworks、Qorvo 和 Broadcomm等幾家廠商手中。濾波器也被Murata、TDK、TAIYO YUDEN、安華高和Qorvo等廠商瓜分。
之所以射頻芯片被國外壟斷,是因為射頻芯片研發難度高,且掌握更多的通信專利,手機在設計的過程中,不但需要考慮蜂窩式的通信,考慮4G、3G、2G的兼容,同時還要考慮與wifi和GPS等器件的共組性問題。也就是説除了單器件的設備問題,在系統架構性方面你需要考慮更多的前端架構是怎樣實現,例如你需要幾根天線做什麼樣的天線分工,所以非常複雜。

當然,國內廠商也一直在發力突破,想要打破國外廠商的壟斷,比如卓勝微,2013年,卓勝微推出第一款GPS射頻低噪聲放大器LNA芯片產品,當年出貨超千萬顆;2014年出貨超1億顆、2015年出貨超3億。成立7年不到,就一躍成為全球第五大、國內技術領先的射頻開關設計公司,客户涵蓋三星、小米、華為、vivo、OPPO等多家手機品牌廠商。其中,射頻開關的全球市場佔有率達5%。
當然,中國的射頻芯片發展也遭到了美國的制裁,比如「諾思微系統」是國內首家FBAR射頻濾波芯片生產公司,濾波器主要可分為聲表面波(SAW)和聲體波(FBAR/BAW)技術的濾波器,和聲表面波(SAW)相比,聲體波(FBAR/BAW)濾波器性能上有明顯優勢,可以讓手機和其他通信器材過濾無線電信號改善通話質量。主要用於手機、平板電腦和GPS等移動電子設備,在5G上也具有重要的應用。

該技術過濾進出的無線信號,這樣用户僅接受和發送其想發送的特定通訊。除了消費品用途外,該技術也被用於一系列軍事和國防通訊技術中。
諾思微系統也是國內少數的專注FBAR濾波器的擁有IDM(垂直整合製造)模式的廠商,建有亞洲首座具有完全知識產權(IP)的FBAR晶圓廠。
諾思微系統的FBAR技術水平已經處於國際領先地位。到目前為止諾思微系統也已推出包括N41在內的多款濾波器產品。諾思微系統在該領域獲得200餘項專利。
然而2015年5月19日,美國邀請諾思維的掌門人張浩來美國參加學術會議,張浩是微機電濾波芯片領域的領軍人物,在美獲得7項專利。
剛下飛機張浩就遭到了拘禁,至此張浩失陷美國6年。在張浩被拘禁期間,諾思發現安華高銷售給蘋果公司的濾波芯片使用了龐慰和張浩研發的專利技術。目前,因為缺少了領頭人,諾思微的發展艱難。

正因為美日在射頻芯片上的壟斷地位,華為為此前的射頻芯片供應商就是美國的思佳訊等,2018年就改為荷蘭的恩智浦和日本的村田,此外還有部分自研和卓勝微等中企。不過,射頻芯片技術很難做到100%去美化。比如,5G射頻芯片肯定要涉及到2G3G、這怎麼可能繞得開高通。
不過,去年6月份,飛驤科技就已經宣佈正式發佈一套完整的5G射頻前端方案,實現了兩個第一:第一套完整支持所有5G頻段的國產射頻前端解決方案和第一套採用國產工藝實現5G性能的射頻前端模塊。該中企強調,其5G產品完全基於自主研發的發明專利和專有技術,芯片製造工藝也完全採用國產廠商三安光電的砷化鎵工藝。

可以預見,在國產芯片廠商的共同發力之下,未來華為缺少射頻芯片的現狀有望得到改善乃至解決,繼續在5G手機賽道上公平地展開競爭。
其實除了射頻芯片之外,我們也可以看到,從目前曝光的名單看,P50的核心供應商包括了像顯示屏供應商京東方,電池供應商德賽電池,聲學零部件供應商瑞聲科技,指紋識別匯頂科技,射頻器件卓勝微,以及比亞迪、信維諾、藍思科技等20多家國內企業。這也説明了,國產企業在半導體材料、射頻芯片、屏幕面板等多個關鍵領域取得了不錯的成績,並且能夠逐步替代美國技術與產品。

這也説明了,在美國的制裁打壓下,國內企業已經明白了,只有自己掌握了核心技術,這樣才能不被美國所制裁打壓,從而保證企業的獨立發展。
胖福的小木屋